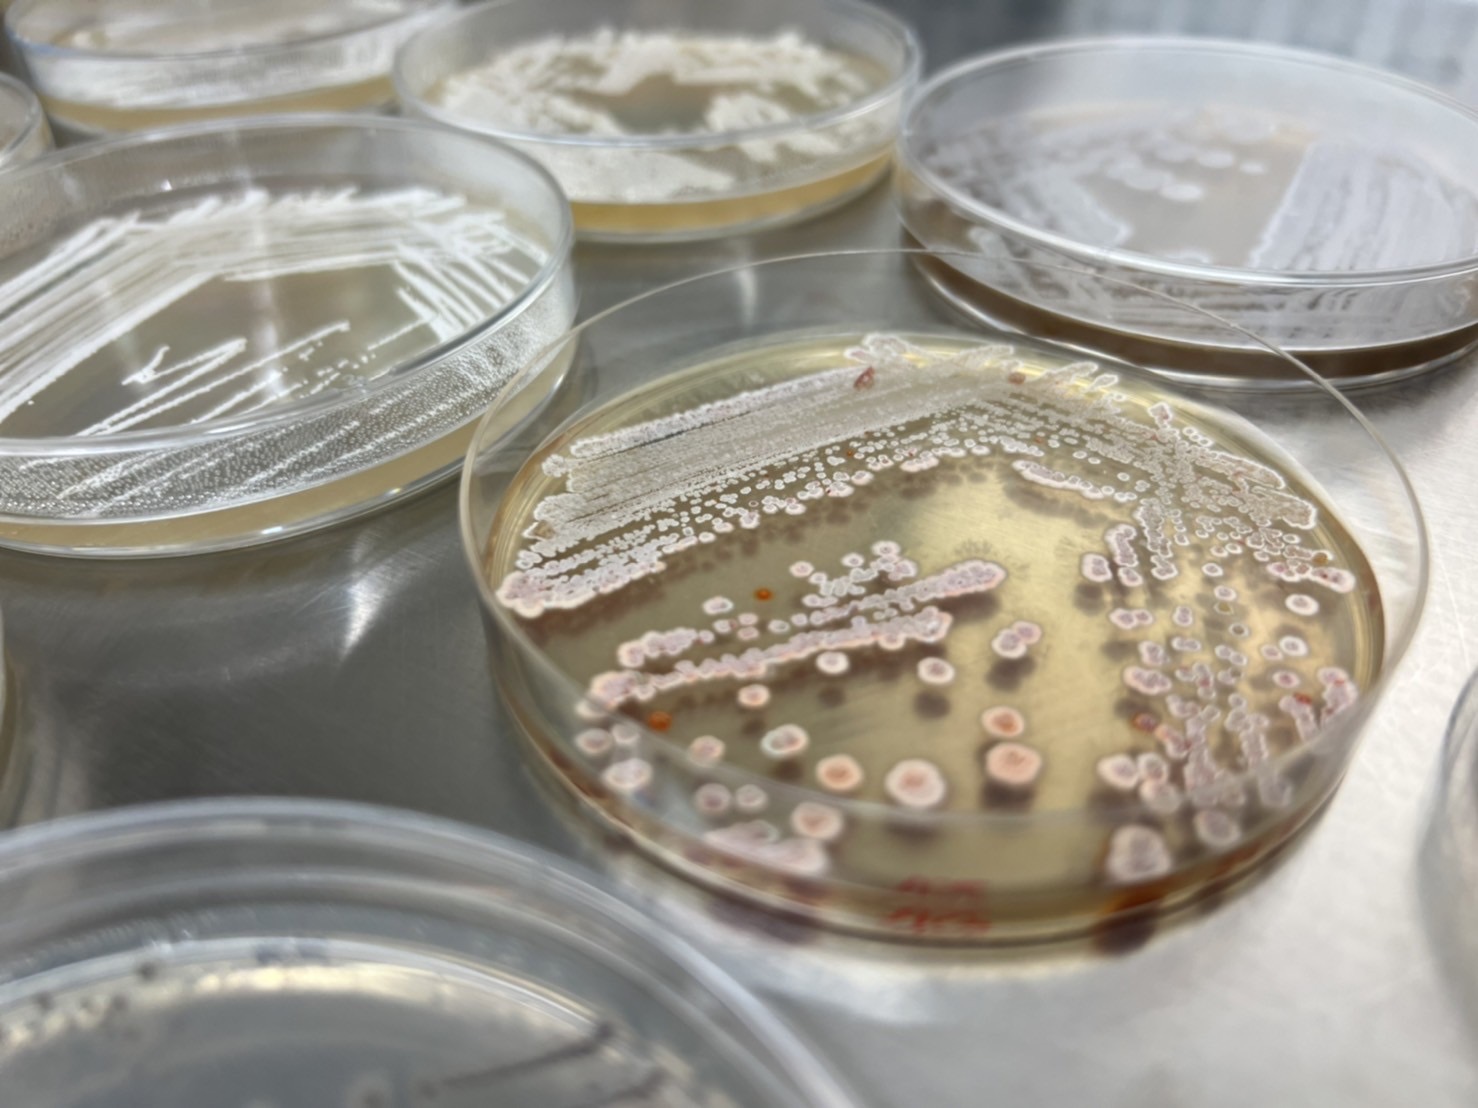

สผ. – สวทช. ร่วมลงนาม MOU พัฒนาฐานข้อมูลกลางด้านความหลากหลายทางชีวภาพของประเทศไทย

เมื่อวันที่ 6 พฤศจิกายน 2567: สำนักงานนโยบายและแผนทรัพยากรธรรมชาติและสิ่งแวดล้อม (สผ.) โดยกองจัดการความหลากหลายทางชีวภาพ จัดพิธีลงนามบันทึกความเข้าใจการจัดทำระบบคลังข้อมูลความหลากหลายทางชีวภาพของประเทศไทย โดยมีนายประเสริฐ ศิรินภาพร เลขาธิการ สผ. และ ศาสตราจารย์ ดร.ชูกิจ ลิมปิจำนงค์ ผู้อำนวยการสำนักงานพัฒนาวิทยาศาสตร์และเทคโนโลยีแห่งชาติ (สวทช.) เป็นประธานการลงนามความร่วมมือ โดยมีวัตถุประสงค์เพื่อเสริมสร้างความร่วมมือในการรวบรวม จัดเก็บ และวิเคราะห์ข้อมูลความหลากหลายทางชีวภาพของประเทศ โดยมีเจ้าหน้าที่ของ สผ. และ สวทช. เข้าร่วมเป็นสักขีพยานในพิธีลงนาม จำนวน 70 คน ณ ห้องประชุม 1001 ชั้น 10 อาคารทิปโก้ 2 ถนนพระรามที่ 6 กรุงเทพฯ
นายประเสริฐ ศิรินภาพร เลขาธิการ สผ. ได้แสดงความมุ่งมั่นในการบูรณาการทำงานร่วมกันระหว่างหน่วยงานผ่านความร่วมมือภายใต้บันทึกความเข้าใจฉบับนี้ เพื่อขับเคลื่อนให้ระบบคลังข้อมูลความหลากหลายทางชีวภาพของประเทศไทยทำหน้าที่ “ศูนย์ข้อมูลกลางด้านความหลากหลายทางชีวภาพของประเทศไทย” ร่วมกับหน่วยงานเครือข่าย และยกระดับการให้บริการข้อมูลความหลากหลายทางชีวภาพที่มีประสิทธิภาพเพิ่มขึ้นอย่างต่อเนื่อง โดยปัจจุบันมีการให้บริการข้อมูลสถานภาพสิ่งมีชีวิตที่ถูกคุกคาม ข้อมูลทะเบียนชนิดพันธุ์ต่างถิ่นที่รุกราน และข้อมูลภูมิสารสนเทศเชิงพื้นที่ และข้อมูลที่สำคัญอื่น ๆ ที่เชื่อมโยงข้อมูลจากหลายภาคส่วน ช่วยประกอบการตัดสินใจ วางแผนการดำเนินงานเพื่ออนุรักษ์คุ้มครองชนิดพันธุ์และพื้นที่แหล่งที่อยู่อาศัย
ศาสตราจารย์ ดร.ชูกิจ ลิมปิจำนงค์ ผู้อำนวยการ สวทช. เปิดเผยว่า สวทช. มีเป้าหมายยกระดับศักยภาพด้านวิทยาศาสตร์และเทคโนโลยีของประเทศ ให้สามารถสนับสนุนการเติบโตของภาคการเกษตรและอุตสาหกรรมอย่างมีประสิทธิภาพและยั่งยืน ซึ่งศูนย์พันธุวิศวกรรมและเทคโนโลยีชีวภาพแห่งชาติ (ไบโอเทค) มีฐานข้อมูลด้านความหลากหลายทางชีวภาพที่สำคัญของประเทศ อาทิ ศูนย์ชีววัสดุประเทศไทย Thailand Bioresource Research Center หรือ TBRC เป็นศูนย์จุลินทรีย์และชีววัสดุชั้นนำในระดับนานาชาติ ที่มีขนาดใหญ่ที่สุดในประเทศไทยและภูมิภาคอาเซียน มุ่งเน้นการรับฝากและให้บริการจุลินทรีย์และชีววัสดุ ธนาคารทรัพยากรชีวภาพแห่งชาติ (National Biobank of Thailand หรือ NBT) เป็นโครงสร้างพื้นฐานสำคัญที่สนับสนุนการอนุรักษ์และจัดเก็บตัวอย่างชีวภาพระยะยาว ช่วยลดความเสี่ยงจากการสูญเสียทรัพยากร และทำหน้าที่เป็นแหล่งอ้างอิงทางวิทยาศาสตร์ที่สำคัญในการพัฒนานวัตกรรมต่างๆ
การลงนามในครั้งนี้ เป็นก้าวแรกที่ทั้งสองหน่วยงานได้ผนึกกำลังต่อยอดฐานข้อมูลความหลากหลายทางชีวภาพของประเทศไทยให้เกิดผลสัมฤทธิ์อย่างเป็นรูปธรรม รวมทั้งเป็นศูนย์กลางที่หน่วยงานและภาคส่วนต่าง ๆ ที่มีการดำเนินงานเกี่ยวกับ ความหลากหลายทางชีวภาพ เพื่ออำนวยความสะดวกให้หน่วยงานต่าง ๆ และประชาชนทั่วไป สามารถเข้าถึงข้อมูลที่เป็นประโยชน์ในการอนุรักษ์และใช้ประโยชน์จากทรัพยากรธรรมชาติได้อย่างมีประสิทธิภาพ เพื่อขับเคลื่อนเศรษฐกิจของประเทศอย่างยั่งยืน